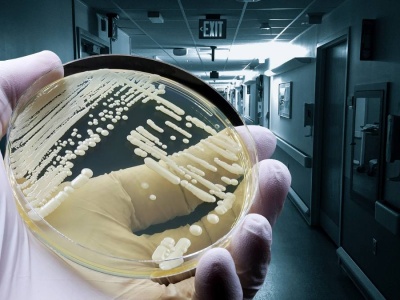

W Europie coraz częściej pojawiają się doniesienia o nowych przypadkach niebezpiecznego grzyba szpitalnego – Candidozyma auris. Patogen, który po raz pierwszy odkryto w 2009 roku w Japonii, dziś jest już endemiczny w Indiach, a liczne ogniska zakażeń odnotowuje się także w południowej Europie. Teraz...
źródło: https://polskiobserwator.de/grozny-grzyb-szpitalny-rozprzestrzenia-sie-w-europie/
dodano: 12-09-2025 00:35:29
Inne znaleziska:
Groźny wirus rozprzestrzenia się w Polsce. Już 10 województw zagrożonych
Groźny wirus rozprzestrzenia się w Polsce. Już 10 województw zagrożonych
Kończy się tegoroczny sezon żniwny i IOR – PIB w Poznaniu informuje w komunikacie o obserwacjach zagrożenia wirusem smugowatej mozaiki pszenicy. Wirus był wykrywany w czasie wegetacji standardowymi metodami diagnostycznymi. Warto przypomnieć, wirusy...
tygodnik-rolniczy.pl
04-09-2025 08:16:05
04-09-2025 08:16:05
Claude AI kontra rachunek szpitalny: chatbot pomógł obniżyć koszty ze 195 tys. do 33 tys. dolarów
Claude AI kontra rachunek szpitalny: chatbot pomógł obniżyć koszty ze 195 tys. do 33 tys. dolarów
Rachunek na 195 tys. dolarów? Dzięki AI udało się zejść do 33 tys. dolarów. Oto historia walki z systemem. Artykuł Claude AI kontra rachunek szpitalny: chatbot pomógł obniżyć koszty ze 195 tys. do 33 tys. dolarów pochodzi z serwisu Alert Medyczny.
alertmedyczny.pl
31-10-2025 02:41:12
31-10-2025 02:41:12
Doda zrobiła rodzicom pokój szpitalny! "Przykre, że większości seniorów nie stać na coś takiego, ale...
Doda zrobiła rodzicom pokój szpitalny! "Przykre, że większości seniorów nie stać na coś takiego, ale na szczęście MNIE T...
Doda pochwaliła się łóżkami pionizującymi, które sprezentowała Wandzie i Pawłowi Rabczewskim. Rodzicie piosenkarki też mają do dyspozycji specjalną łazienkę.
pudelek.pl
21-11-2025 18:57:10
21-11-2025 18:57:10
Szpitalny oddział ratunkowy w nowej odsłonie. Zakończono wielomilionową modernizację
Szpitalny oddział ratunkowy w nowej odsłonie. Zakończono wielomilionową modernizację
Ponad 15,5 mln złotych pochłonęły prace związane z modernizacją oddziału ratunkowego w Regionalnym Szpitalu Specjalistycznym „Latawiec” w Świdnicy. Dyrekcja placówki właśnie poinformowała o zakończeniu przebudowy. – Zmodernizowany SOR to realna popra...
swidnica24.pl
06-02-2026 16:12:03
06-02-2026 16:12:03
Szpitalny oddział postawiony na nogi. 15-latek „żartował” z bomby dla 100 zł
Szpitalny oddział postawiony na nogi. 15-latek „żartował” z bomby dla 100 zł
Rzeszów News Do skandalicznego zdarzenia doszło w miniony piątek późnym wieczorem w jednym z rzeszowskich szpitali. Przed godziną 23:00 na telefon służbowy Szpitalnego Oddziału Ratunkowego przy ul. Lwowskiej zadzwonił mężczyzna z mrożącą krew w żyłac...
rzeszow-news.pl
13-05-2026 14:49:07
13-05-2026 14:49:07
Produkowana przez nas hydraulika jest montowana w wielu sztandarowych produktach polskiej zbrojeniówki, np. Pojazdach gąsienicowych. Nie są to elementy spektakularne, ale spełniają zasadniczą rolę - mówi Rafał Worek, wiceprezes Ponaru Wadowice.
radar.rp.pl
05-09-2025 14:31:06
05-09-2025 14:31:06
"Całujące pluskwy" z pasożytami. W USA rozprzestrzenia się choroba Chagasa
"Całujące pluskwy" z pasożytami. W USA rozprzestrzenia się choroba Chagasa
Choroba Chagasa, wywoływana przez tzw. całujące pluskwy, staje się coraz większym zagrożeniem w USA. Z najnowszego raportu amerykańskiego Centrum Kontroli i Zapobiegania Chorobom, który przytacza stacja CBS News, wynika, że przypadki tej potencjalnie...
rmf24.pl
08-09-2025 22:05:20
08-09-2025 22:05:20
„Choroba całujących pluskiew” rozprzestrzenia się. Zarażonych 280 tys. osób?
„Choroba całujących pluskiew” rozprzestrzenia się. Zarażonych 280 tys. osób?
Wywoływana przez tzw. całujące się pluskwy choroba Chagasa pojawia się w kolejnych regionach USA. Centrum Kontroli i Zapobiegania Chorobom (CDC) donosi o potwierdzonych przypadkach już w 8 stanach.
wprost.pl
09-09-2025 10:17:08
09-09-2025 10:17:08
Choroba niebieskiego języka rozprzestrzenia się po Polsce! Wirus BTV-3 dotarł do kolejnego województ...
Choroba niebieskiego języka rozprzestrzenia się po Polsce! Wirus BTV-3 dotarł do kolejnego województwa
Główny Lekarz Weterynarii poinformował o 11. w 2025 roku ognisku choroby niebieskiego języka (Bluetongue – BTV) w Polsce. 15 października potwierdzono obecność wirusa serotypu 3 (BTV-3) w gospodarstwie utrzymującym bydło w powiecie strzelecko-drezden...
agronews.com.pl
21-10-2025 13:06:17
21-10-2025 13:06:17
Groźna choroba rozprzestrzenia się w popularnej restauracji typu fast-food. Uważano ją za wymarłą
Groźna choroba rozprzestrzenia się w popularnej restauracji typu fast-food. Uważano ją za wymarłą
Przypadek zachorowania na Odrę w Niemczech: W powiecie Erding (Bawaria) służby sanitarne biją na alarm po potwierdzeniu przypadku choroby, którą większość z nas kojarzy raczej z podręczników historii medycyny niż z dzisiejszych czasów. Co gorsza, oso...
polskiobserwator.de
06-11-2025 15:12:22
06-11-2025 15:12:22